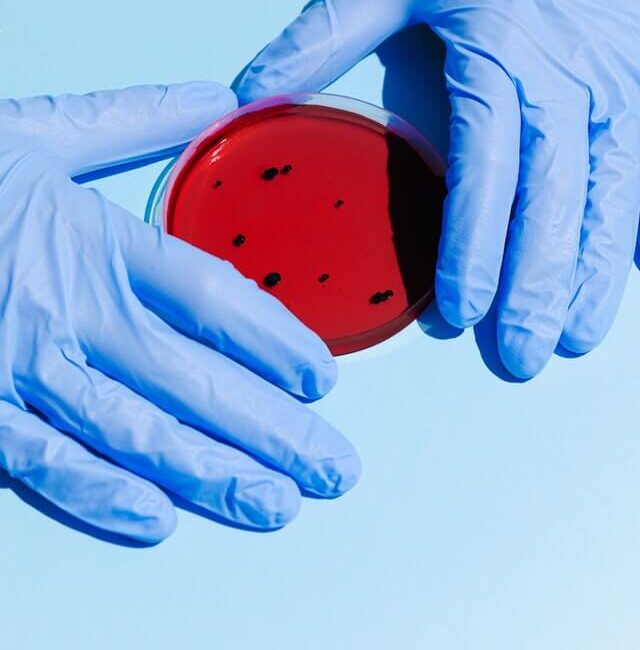
top cesarean doctor in lucknow

Cesarean Delivery Section ( C Section )
Cesarean Delivery (C-Section) in Lucknow – Safe Surgical Birth with Dr. Shalini Singh
Childbirth is a life-changing event, and while many mothers prefer a normal vaginal delivery, sometimes a Cesarean delivery (C-section) is the safest option for mother and baby. With modern medical advancements, a C-section is a safe, reliable, and well-practiced procedure worldwide.
At Regency Hospital, Khurram Nagar, Lucknow, Dr. Shalini Singh, a trusted gynecologist, obstetrician, and top cesarean doctor in lucknow, offers expert care in both planned and emergency C-sections. With years of experience in high-risk pregnancy management and advanced obstetrics, Dr. Shalini ensures that mothers in Lucknow and Uttar Pradesh receive the highest standards of safety, comfort, and care during cesarean births.
What is Cesarean Delivery (C-Section)?
A Cesarean delivery (C-section) is a surgical procedure in which the baby is delivered through an incision in the mother’s abdomen and uterus. It may be:
- Planned (Elective) C-Section – Scheduled in advance due to medical reasons or patient preference
- Emergency C-Section – Performed during labor if complications arise for mother or baby
C-sections are common and safe when performed by experienced gynecologists with modern facilities.
When is a Cesarean Delivery Needed?
C-sections may be recommended in the following situations:
- Baby’s position – Breech (feet-first) or transverse lie
- Previous C-section – Some women require repeat cesarean delivery
- Multiple pregnancies – Twins, triplets, or more
- Prolonged or stalled labor – When natural progress stops
- Fetal distress – Baby’s heartbeat indicates stress
- Large baby (Macrosomia) – When vaginal birth may be difficult
Benefits of Cesarean Delivery ( C-Section )
While a normal vaginal birth is preferred, C-sections have several advantages when medically indicated:
- Safe for high-risk cases – Protects mother and baby in complicated pregnancies
- Planned and predictable – Scheduled C-sections reduce last-minute emergencies
- Prevents birth trauma – Beneficial in cases of large baby or difficult position
- Life-saving in emergencies – Quick intervention for fetal distress or complications
- Option after failed normal labor – Ensures safe delivery when progress halts
Step-by-Step: How a C-Section is Performed
Preparation – Vitals checked; anesthesia administered (spinal/epidural preferred)
Incision – A small cut (usually horizontal, low bikini-line) is made on the abdomen
Delivery – Uterus is opened and the baby is delivered safely
Placenta removal – Placenta is removed and uterus cleaned
Closure – Uterus and abdominal wall are stitched with dissolvable sutures
The entire procedure usually takes 30–60 minutes, and mothers can see their baby almost immediately after birth.
Recovery After Cesarean Delivery
Recovery from a C-section is longer compared to normal delivery, but with proper care, mothers heal well:
- Hospital stay: Typically 3–5 days
- Pain management: Medications ensure comfort post-surgery
- Mobility: Walking encouraged within 24 hours to prevent clots
- Scar healing: Most incisions are small, low, and heal with minimal scarring
- Breastfeeding: Usually starts within hours of delivery
- Full recovery: 6–8 weeks on average, with regular follow-ups
Dr. Shalini Singh provides detailed postnatal care and counseling to ensure smooth recovery.
Why Choose Dr. Shalini Singh for Cesarean Delivery in Lucknow?
Highly Qualified Expert
MBBS, MS (Obs & Gyn), Gold Medalist with advanced training in obstetrics & gynecology
Modern Facilities
Regency Hospital’s OT is equipped for safe C-sections with NICU support for newborns
Compassionate Care
Focus on emotional support and patient comfort alongside medical safety
High-Risk Pregnancy Specialist
Extensive experience in managing complex pregnancies requiring cesarean delivery
Safe Surgical Techniques
Minimally invasive approach with small incisions and fast recovery
What to Expect: Before, During & After C-Section
Before Delivery
- Detailed consultation to discuss indications and options
- Pre-operative investigations (blood work, scans, anesthesia clearance)
- Counseling about procedure and recovery
During Delivery
- Performed under spinal or epidural anesthesia (mother awake but pain-free)
- Baby delivered within minutes after incision
- Monitoring of mother and baby throughout
After Delivery
- Rest and pain relief in recovery room
- Early initiation of breastfeeding and mother-baby bonding
- Regular follow-ups to monitor scar healing and uterine recovery

Book Your Cesarean Delivery Consultation in Lucknow
If you are planning your childbirth or have been advised a C-section, you deserve the safest hands and modern facilities. With Dr. Shalini Singh, you receive advanced obstetric care, personalized attention, and full support throughout your journey.
Frequently Asked Questions (FAQs)
Yes, when performed by an experienced gynecologist like Dr. Shalini Singh in a modern hospital, it is very safe.
Most mothers recover in 6–8 weeks, though light activities resume within days.
No, most incisions are low horizontal (bikini cuts) and heal with minimal visible scarring.
Yes, in some cases VBAC (Vaginal Birth After Cesarean) is possible, depending on your medical history.
No, breastfeeding can usually start within hours after surgery.
Risks may increase slightly, but with expert care, repeat cesarean deliveries are safe.
Costs vary depending on hospital facilities and complications, but Regency Hospital offers affordable and transparent packages compared to metro cities.
